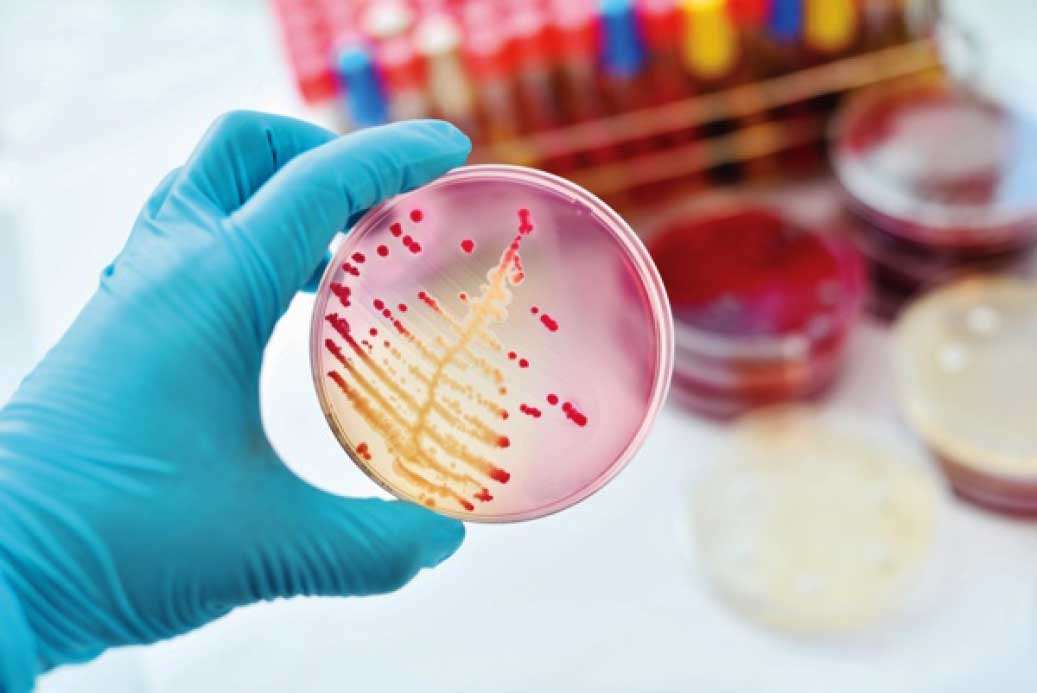
#

Commercial agricultural has largely been depended upon conventional synthetic inputs which are proven to be disastrous for environment and unsustainable.
Our innovative IP protected bio-organic solutions are designed to provide complete nutritional needs of the plants and efficiently manage common pest and disease issues resulting in yield equivalent to or more than conventional.


Super efficient Bio fertilizer | Health Regulator
Growth Promoter | Bio Pest & Fungal Control Agents
Hormonal supplement | Immunity booster
Bio-Composter | Soil Detoxifier/ Moderator
Probiotics | Food suppliments,vitamins,enzymes Growth factors
LEARN MORE

Our technology is unique so there is a need of disseminating the knowledge to the farmers/ users for them to adopt to this technology. As most of our inputs are microbial solutions, handling and application doesn’t follow the conventional plug and play model like in synthetic inputs. Moreover, applications require scientific scheduling to timely meet nutritional needs of the plants and to take preemptive measures for controlling pests & diseases.
to effectively utilize this technology and maximize the benefits
LEARN MORE




for maximizing the yield and most importantly refinement of quality
LEARN MORE

Golf Course, Tennis Court, Cricket Field, Football Ground
The finals of U17 Football World Cup’17 in Yuva Bharati Stadium, Kolkata was conducted only after the grass was restored by our products to the satisfaction of FIFA in a record 18 days time
LEARN MORE



NO HARMFUL EFFECT on
mammals, earthworms, birds, snails & beneficial insects e.g. honeybees, butterflies, ladybirds etc




BomLife is a biotech company engaged in
RESEARCH, INNOVATION & DEVELOPMENT
of Unique Bio-Organic Solutions
Our mission is to fight global warming and climate change by innovating bio-organic solutions for sustainable models of agriculture, pisciculture, animal husbandry, bio-waste management, green energy…
LEARN MORE

As a result oriented company we don’t ride on conventional marketing techniques to establish our brand. Instead we want to leave it to the farmers to do it – organically.
Our distribution network involves value chains with farmer groups or organized farms whom we help in adopting to Hi-tech Organic successfully.

